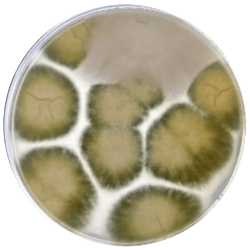

- info@solucionesdehesasana.com
- 689 124 139
- Campo Jerez, N-435, km.74, 06380 Jerez de los Caballeros, Badajoz
Líderes en Regeneración de la Dehesa
Enfoque único en recuperación de la microbiota del suelo
Somos REGENERACIÓN SALUD ECONOMÍA CIRCULAR








REGENERACION DE ECOSISTEMAS, SALUD Y ECONOMIA CIRCULAR, IGUAL A FUTURO
Regeneración de la Dehesa
Soluciones Dehesa Sana es un proyecto de investigación multidisciplinario que se centra en el desarrollo de soluciones biotecnológicas sostenibles para fortalecer la inmunidad y la resiliencia de las plantas frente a microorganismos patógenos, incluido Phytophthora cinnamomi, conocido como el «destructor de plantas».
Este proyecto cuenta con la colaboración de incubadoras de alta tecnología, la Universidad Complutense y centros de investigación. Su objetivo es avanzar en el desarrollo de soluciones innovadoras para proteger los ecosistemas naturales y los sistemas agrícolas de los efectos adversos de estos patógenos.
Somos los Guardianes de la Dehesa
SALUD en las PLANTAS - SALUD en los ANIMALES - SALUD en las PERSONAS
ENFERMEDAD DE LA SECA
El problema de la seca
Phytophthora, apodado como «El Destructor de Plantas«, es un oomiceto parásito que ataca a aproximadamente 5.000 especies de plantas leñosas, arbustivas y herbáceas. Su acción desencadena la podredumbre de las raíces, lo que puede resultar en la muerte rápida de la planta o pasar desapercibido durante años debido a la falta de síntomas evidentes. El decaimiento de las poblaciones de encinas y alcornoques conlleva preocupación en diversas actividades económicas relacionadas.
Un claro objetivo
NUESTRA HISTORIA
¿Es posible la Regeneración de la Dehesa
Hemos descubierto que sí, a través de la regeneración del suelo, regeneramos las plantas, aumentamos el ciclo corto del agua, proporcionamos salud a los animales y a los seres humanos en diferentes ecosistemas.
Basamos la regeneración en restablecer la microbiota del suelo con microorganismos AUTÓCTONOS
Microorganismos autóctonos beneficiosos
Regenerar hoy el suelo que sostiene el mañana
Misión
Regenerar la dehesa desde el suelo mediante soluciones biotecnológicas sostenibles, basadas en la ciencia y en el uso de recursos autóctonos, para restaurar el equilibrio del ecosistema y garantizar su viabilidad productiva a largo plazo.
Visión
Ser la referencia en regeneración de dehesas y suelos agroforestales, liderando un modelo en el que sostenibilidad ambiental, rentabilidad económica y compromiso con el territorio avanzan de la mano.
Valores
Ciencia aplicada al campo
Convertimos investigación avanzada en soluciones reales, eficaces y medibles sobre el terreno.
Respeto por el ecosistema
Trabajamos con la naturaleza, no contra ella. Restauramos procesos biológicos en lugar de forzarlos.
Innovación con propósito
Desarrollamos tecnología útil, escalable y alineada con los retos ambientales y productivos actuales.
Compromiso con el territorio
Creemos en el valor del medio rural, el empleo cualificado y la protección de un patrimonio natural único.
Impacto duradero
No buscamos soluciones rápidas, sino regeneración profunda que asegure futuro ambiental, económico y social.
I + D + I Regenerativa
EL MOTOR DEL CAMBIO, NUESTRO PRESENTE Y FUTURO
Con investigación interdisciplinar, promovido por el departamento I+D de Joselito y con sello de investigación Complutense, financiado por CDTI, busca regenerar los suelos de la dehesa como vía para enriquecer y mejorar la salud dentro de la estrategia One Health.
Nuestros Proyectos de Regeneración

DEHELIFE
Desarrollo de agentes de control biológico autóctonos para el restablecimiento del equilibrio de suelos de la dehesa- PID-CDTI

BIOVSCINN
Búsqueda de componentes bioactivos autóctonos en plantas para combatir patógenos vegetales-Junta de Extremadura – D57

LOWCARBON
Estudio de la huella de carbono de la actividad en la dehesa y planteamiento de estrategias de mitigación -Financiación propia.

QCOMPOST
Tierra Joselito: Investigación y desarrollo de compostaje de alta calidad- Financiación propia

WOOLVALUE
Proyecto EUROPEO -ECONOMÍA CIRCULAR UP2CIRC-Junta de Extremadura

UP2CIRC
Proyecto EUROPEO - UP2CIRC. European Circular Economy Stakeholder Platform. A joint initiative by the European Commission and the European Economic and Social Committee

CDTI CUR
Control Biológico del Curculio Elephas en Quercus para Optimizar el Perfil Oleico del Cerdo Ibérico
Equipo Humano
Con un equipo conformado por expertos de diversas instituciones, como universidades, centros de investigación y incubadoras de alta tecnología. Compuesto por 32 técnicos, que están desarrollando soluciones que muestran resultados prometedores en la protección de estas especies, que ya han demostrado que los microorganismos autóctonos beneficiosos (hongos con propiedades antimicrobianas) tienen un 100% de inhibición in-vitro frente al patógeno Phytophthora cinnamomi.
BIORREGULADOR DE LOS SUELOS
Efecto inhibidor de P.cinnamomi y bioestimulador de encinas y alcornoques.

MICROORGANISMOS AUTÓCTONOS VIVOS
Sustrato fermentado con poblaciones mixtas controladas de microorganismos vivos.

PRINCIPIOS ACTIVOS
Sustrato fermentado de forma controlada que ya contendrá metabolitos de acción directa.

SUSTRATO COMPLETO
No se realiza la purificación de los biocompuestos, rico en metabolitos y sus posibles relaciones simbióticas.
Compost Tierra Joselito
Se trabaja en la elaboración del Compost-Tierra Joselito utilizando los residuos de poda, plantas verdes y residuos orgánicos de origen animal, enriquecidos con ingredientes naturales como prebióticos, probióticos y postbióticos. Este proceso es clave para ayudar a revitalizar los suelos degradados no solamente en las dehesas, sino también en diferentes ambientes, incluso en entornos urbanos.







